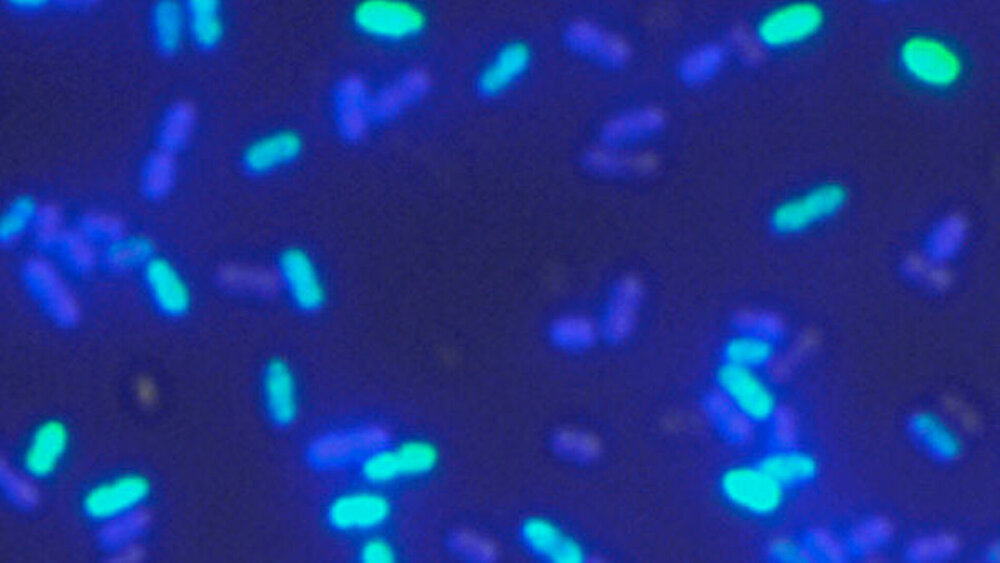

Kariesverursacher überlebt durch Kommunikation
Um in ihrer Umgebung zu überleben und wettbewerbsfähig zu bleiben, müssen sich Bakterien ständig neue Eigenschaften aneignen. Häufig dadurch, dass sie fremde DNA aufnehmen und in ihr eigenes Genom integrieren. Das gilt auch für das Bakterium Streptococcus mutans, das als Hauptverursacher von Karies gilt.
Im menschlichen Zahnbelag steht das Bakterium in ständiger Konkurrenz mit anderen Keimen, mit denen es ums Überleben kämpft. Dafür integriert das Bakterium DNA aus seiner Umgebung in sein eigenes Genom. Die Fähigkeit dazu nennt man genetische Kompetenz. "Dass die Kompetenz durch Quorum Sensing, also durch Zell-Zell-Kommunikation, gesteuert wird, war bereits bekannt. Wir haben nun erstmals genau gezeigt, wie die dafür entscheidenden Signale, XIP und CSP, miteinander interagieren", sagt Prof. Irene Wagner-Döbler, Leiterin der Arbeitsgruppe Mikrobielle Kommunikation am HZI in einer Pressemitteilung. "Dazu haben wir die Promotoren der beteiligten Gene entlang der gesamten Signalkette mit fluoreszierenden Proteinen gekoppelt."
Darüber hinaus demonstrierten Wagner-Döbler und ihr Team, dass mit der Kompetenz auch noch ein weiterer Mechanismus sehr eng zusammenhängt: die Bakteriozinsynthese. Bakteriozine sind Peptidantibiotika, die andere Streptokokken töten. "Unsere Ergebnisse zeigen, dass die Ausbildung der Bakteriozine über dasselbe Gen reguliert wird, das auch die Fähigkeit zur Kompetenz kontrolliert", sagt Dr. Michael Reck, Wissenschaftler in der Gruppe um Wagner-Döbler und Erstautor der Studie. "Beide Prozesse sind also viel enger miteinander verknüpft, als bisher angenommen."
Streptococcus mutans tötet andere Bakterien und nutzt deren Erbsubstanz
Die enge Verzahnung beider Quorum Sensing Systeme lässt den Schluss zu, dass Streptococcus mutans nicht nur andere Bakterien tötet um sich der Konkurrenz zu entledigen, sondern die freiwerdende Erbsubstanz gleich noch nutzt um sein eigenes Gen-Repertoire zu erweitern. "Diese Fähigkeit sichert ihm das Überleben trotz großer Konkurrenz innerhalb seiner natürlichen Umgebung und erklärt, warum er so häufig auftritt", sagt Wagner-Döbler.
Langfristig könnten die neugewonnenen Einblicke in die Mechanismen außerdem Ansatzpunkte für die Bekämpfung des Erregers liefern. "Wenn wir genau wissen, wie ein Erreger überlebt und in seiner natürlichen Umgebung agiert, können wir auch Strategien entwickeln, wie wir seine Ausbreitung vermindern", sagt Reck.
Reck M, Tomasch J, Wagner-Döbler I (2015) The Alternative Sigma Factor SigX Controls Bacteriocin Synthesis and Competence, the Two Quorum Sensing Regulated Traits in Streptococcus mutans. PLoS Genet 11(7): e1005353.DOI:10.1371/journal.pgen.1005353.